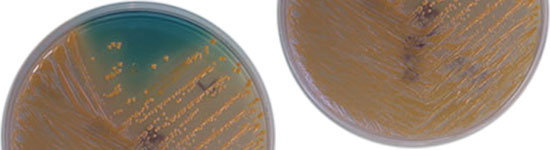

Swine can carry foodborne pathogenic bacteria that cause human illness, most notably Salmonella. Slaughter facilities in the U.S. and EU reduce the horizontal and vertical spread of pathogens on carcasses and finished products. However, we can enhance the effectiveness of the post-slaughter treatments by reducing the food-borne pathogens that enter the abattoir. Unfortunately, food-borne pathogens that cause human illnesses often do not cause illness in swine, making detection and elimination of these pathogens very difficult.
All swine producers want to produce a safe product. However, pathogen reduction comes at a cost, and unless a pathogen-reduction strategy improves animal health or profitability, then producers using these techniques are disadvantaged. Therefore, if we can treat swine through dietary interventions, we can reduce pathogen shedding without adding new steps for producers.
Several dietary strategies have been suggested to reduce intestinal populations of food-borne pathogens in swine. In general, these can be grouped into pathogen-killing and competition-elimination strategies. Pathogen-killing strategies try to specifically kill the pathogenic bacteria, while competition-elimination strategies use other bacteria or yeast populations to eliminate pathogens by reducing their role in the gut ecology.

Pathogen-killing strategies
Pathogen-killing strategies are typically thought of primarily as the use of medically-important antibiotics. However, the use of these antibiotics for growth enhancement or prophylactic treatment is now banned in the EU. Alternative pathogen-killing treatments include: 1) vaccination; 2) antimicrobial proteins produced by bacteria; and 3) alternative antimicrobial compounds that specifically target pathogenic bacteria.
Most vaccines used in swine inhibit pathogens that cause morbidity or mortality in pigs. Many of the human pathogenic Salmonella do not cause illness in swine, thus it is difficult to develop a host immunological response to non-pathogenic bacteria. Several vaccines against Salmonella strains responsible for swine disease outbreaks have been developed. Also, vaccines that combat post-weaning E. coli edema disease in weaning pigs have been developed. However trials using vaccines against foodborne Salmonella spp. in swine have not been conclusive.
Some bacteria produce antimicrobial proteins that kill other bacteria, called bacteriocins or colicins. These proteins can be used to control various members of the bacterial population of the gut (e.g. Salmonella and E. coli) but large scale production for use in animal feeding has been too expensive. However molecular techniques have allowed production to be cheaply scaled up, so that these antimicrobial proteins can now be determined in production swine feeding trials. In preliminary studies post-weaning diarrhea-causing E. coli and Salmonella populations were reduced by feeding colicins to weaned pigs.
Sodium chlorate is a chemical that takes advantage of the nature of E. coli and Salmonella and kills them. These bacteria can convert nitrate to nitrite, but the enzyme responsible for this activity does not recognize that chlorate is different than nitrate. Chlorate is converted to chlorite, which kills the bacteria. Bacteria that do not convert nitrate to nitrite are unaffected by chlorate. Chlorate can be included in feed or water and reduces Salmonella and E. coli populations in swine and is currently in development for release as a commercial product.
Competition-elimination strategies
The goal of competition-elimination strategies is to fill all ecological niches in the gastrointestinal tract to keep pathogens out. If pathogens cannot get their essential nutrients nor find a location to live in the gut, then they cannot persist in the live animal. Various strategies have been proposed for use in swine, include:1) introduction of a “healthy pig” microbial population (competitive exclusion); 2) providing a limiting nutrient “prebiotic” that allows a “normal” microbial population to expand, or 3) addition of a microbial supplement such as a direct-fed-microbial (DFM) to improve animal health.
A promising new defined competitive exclusion culture being developed in our laboratory for use in swine is currently in field trials prior to release. It reduces Salmonella spp. populations in swine, more importantly it significantly reduces post-weaning death and productivity losses, resulting in an increase in profitability. Prebiotics have been too expensive for widespread use in swine to date, and DFM have been used with mixed results on pathogen shedding and productivity depending on the type of culture used. Additionally, the use of antibiotics simultaneously with competitive-enhancement strategies can antagonistically eliminate the benefits of these treatments.
Conclusions
Dietary strategies can reduce foodborne pathogens in pigs. Many of these methods can be used in conjunction with one another to synergistically reduce foodborne pathogens. However, some of these will be counterproductive if used in combination. Several new methods are on the near horizon for use in improving the safety of pork products at the live animal level.